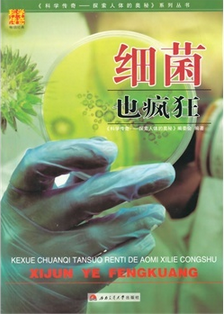

细菌也疯狂 - 中国高校教材图书网
|
书名: |
细菌也疯狂
|
| ISBN: | 9787564335083 |
责任编辑: | |
| 作者: |
《科学传奇——探索人体的奥秘》编委会著
相关图书
|
装订: | 平装 |
| 印次: | 1-1 |
开本: | 16开 |
| 定价: |
¥28.00
折扣价:¥26.60
折扣:0.95
节省了1.4元
|
字数: |
|
| 出版社: |
西南交通大学出版社 |
页数: |
216页
|
| 出版日期: |
2015-06-01 |
每包册数: |
|
| 国家规划教材: |
|
省部级规划教材: |
|
| 入选重点出版项目: |
|
获奖信息: |
|
|
|
| 内容简介: |
|
微生物王国,一个充满传奇色彩的王国。人类诞生之日,就免不了要与其纠葛不尽。当呱呱坠地的婴儿,还没来得及看清这个世界,微生物却已经做好移民的准备,在数小时内全部入住到这个懵懂未开的世界里。和他一起同生共长。斗转星移,人类在感叹十年如一梦时,微生物却已发展得比人体的细胞还要多,这个在体重中占有绝对分量的王国,人类又知晓多少?它们没有口,如何吃饭?它们没有胃,如何消化食物?它们没有脚,怎么行走?它们没有漂亮的衣服,为什么总是那么花枝招展?作为地球上最原始最有生命力的生命,它们是否具有自己独特的生存法则和游戏规则?……不管人类喜欢与否,它们都和人类一起斩荆劈棘,一路走来,不离不弃,相伴终生。直到人类轰然倒下,它们也随之消亡,这样的忠贞,即使人类的亲密伴侣也未必做到。漫漫人生,演绎了多少人间悲欢离合,而在人体这个小小的舞台上,同样也上演了多少精彩的故事,下面,就让我们推开人体这扇门,一览微生物王国的秘密生活……
|
| 作者简介: |
|
|
| 章节目录: |
|
|
| 精彩片段: |
|
|
| 书 评: |
|
|
| 其 它: |
|
|
|

 中国大学出版社协会 |
首页 |
宏观指导 |
出版社天地 |
图书代办站 |
教材图书信息 |
教材图书评论 |
在线订购 |
教材征订
中国大学出版社协会 |
首页 |
宏观指导 |
出版社天地 |
图书代办站 |
教材图书信息 |
教材图书评论 |
在线订购 |
教材征订

